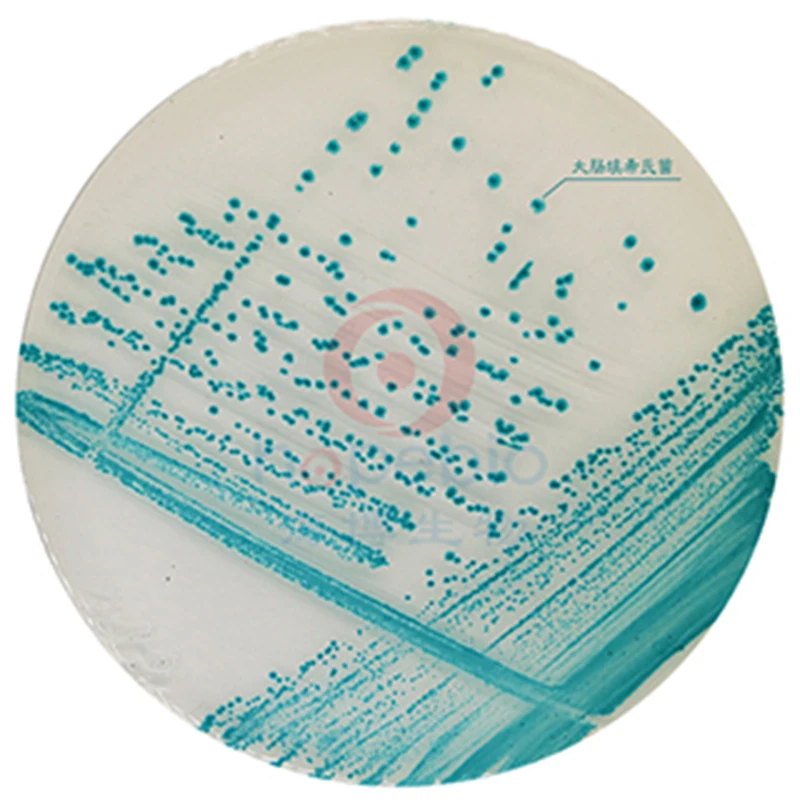
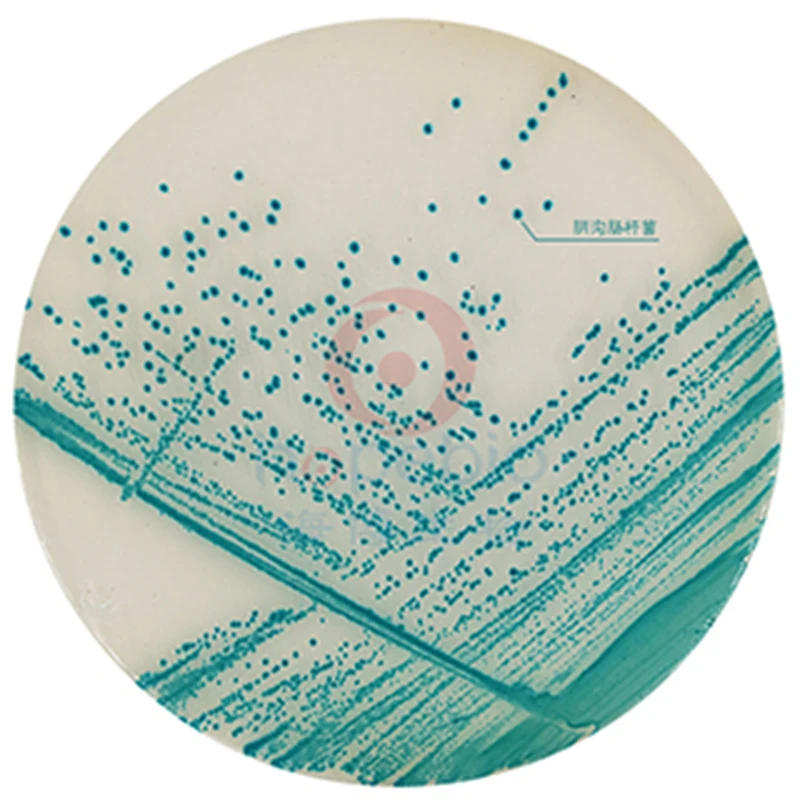

1000 мл Coliform хромогенная среда|Центрифужные трубки| |
Сохраните в закладки:






История цены
*История изменения цены! Указанная стоимость возможно, уже изменилось. Проверить текущую цену - >
| Месяц | Минимальная цена | Макс. стоимость | Цена |
|---|---|---|---|
| Sep-17-2025 | 14585.80 руб. | 15314.67 руб. | 14949.5 руб. |
| Aug-17-2025 | 14462.81 руб. | 15185.16 руб. | 14823.5 руб. |
| Jul-17-2025 | 12133.4 руб. | 12740.26 руб. | 12436.5 руб. |
| Jun-17-2025 | 14217.33 руб. | 14928.16 руб. | 14572.5 руб. |
| May-17-2025 | 12379.89 руб. | 12998.89 руб. | 12688.5 руб. |
| Apr-17-2025 | 13972.58 руб. | 14671.83 руб. | 14321.5 руб. |
| Mar-17-2025 | 13849.2 руб. | 14541.93 руб. | 14195 руб. |
| Feb-17-2025 | 13727.7 руб. | 14413.99 руб. | 14070 руб. |
| Jan-17-2025 | 13604.0 руб. | 14284.67 руб. | 13944 руб. |
Новые товары
Прозрачная пластиковая центрифужная пробирка 1 5 мл с Защелкивающейся Крышкой
Прямое обычное стекло THEMIS YUHETEC для сирены 2 24 22 мм/Сирена 3 GTA/faraoh mini мл 5
Микро-пробирка 0 2 мл 50 пробирок прозрачная пластиковая трубка контейнер научные
Малый размер съемная полка центрифуги для 10 мл/15 мл 50 два назначения - купить по
Обычная стеклянная трубка для Coil Father King RDTA/RTA лабораторные принадлежности
Одноразовые Микроцентрифужные пробирки с коническим дном 1000 мл 0 2 шт. - купить по
Криопарные трубки 500 шт./лот 1 8 мл (2 мл) криогенные флаконы пластиковые реагентные
25 см пластиковая пробирка 50 мл лабораторные анализаторы замораживающие трубки
Характеристики
1000 мл Coliform хромогенная среда|Центрифужные трубки| |
Описание товара
1000 мл Coliform хромогенная среда
Используется для быстрого обнаружения колиформ в еде, воде, молоке, мороженом и мясных продуктах. Колиформы-сине-зеленые, другие бактерии-желтые или бесцветные, а Грамположительные бактерии ингибируются Специальные питательные вещества ------------ 34,55 г/л Хромогенный агент ----------- 0,35 г/л Агар---13. 0 г/л PH 7,0-7,2 --------------------- 25 ℃
Применение
Взвесьте 47,9 г этого продукта и добавьте 1000 мл дистиллированной воды. Нагрев растворяется без остановки перемешивания. Кипятите не более 1 минуты. Треугольные бутылки, 121℃ стерилизация автоклава в течение 15 минут. 1 мл приготовленного образца раствора добавили в центр стерильной посуды диаметром 9 см, а затем залили в культиватор для охлаждения до 15 мл при 45-50 ℃. После смешивания, после затвердевания, культура была инвертирована на 36℃ в течение 18 ~ 24 ч. Или при охлаждении до 45-50 ℃, налейте в стерильные блюда, после того, как агар полностью Затвердеет, положите его вверх дном в инкубатор на 37 ℃ в течение 1-2 часов, добавьте 1 мл раствора образца с соответствующей степенью разбавления, распределите его на культивирующую среду и распределите его при 36 ℃ в течение 18-24 ч.
Шаги
1. Подготовить образец раствора в соответствии с национальным стандартом, стандартом SN, стандартом FDA или другими способами; 2. Возьмите 1 мл раствора образца, добавьте его в цвет развития среды и Охладите его до 45-50 ℃, Смешайте его или распределите на пластине; 3. Культивированный при 36 ℃ в течение 18 ~ 24 ч, выбранные пластины с 30 ~ 200 колоний и подсчитывают типичные колонии колиформ на плитах. Колонии колоний обычно сине-зеленые, другие-бесцветные или желтые. Общая коллиформа = сине-зеленые колонии; 4. Бактериальные колонии предполагаемой колы могут быть прививаны на питательные агарные пластины, культивированные при 36 ℃ в течение 12-16 часов, и Одиночная колония выбирается для теста на ферментацию колиформ BGLB.
Качество Управление
1, внешний вид Порошок сухой среды однородный, имеет хорошую плавность и молочно-белый. Подготовленные пластины были прозрачными бесцветными твердыми средами. 2. Микробиологический тест






Трекер стоимости
Отзывы покупателей
Новые отзывы о товарах
Красивые, яркие, интересные и очень оригинальные серьги. Мне они понравились буквально с первого взгляда. Нисколько не пожалела, что их заказала.... Читать отзыв полностью...

Забавная маска, довольно страшная. Цена не высока, по размерам угадали. Главное в маске, эффект неожиданности. Шутка удалась. Для маскарада и... Читать отзыв полностью...

Качество порадовало, плюс довольно модная и вместительная. Ценник свои оправдывает. Рекомендовать могу смело, Как доставили, качество оценил, брака не выявил,... Читать отзыв полностью...
Нисколько не пожалела, что заказала здесь светоотражающий Зонт Godox. СТоимост оказалась вполне доступной. Просто в других интернет-магазинах видела такой же... Читать отзыв полностью...
Заказала эти серьги из стерлингового серебра 925 пробы и никапельки не пожалела. Они просто великолепны, даже еще лучше в жизни,... Читать отзыв полностью...

Купила дочкам две такие коробочки, хранят там свои сокровища))) бусинки, бижутерию, поделки. Им очень нравится, и мне тоже, нигде ничего... Читать отзыв полностью...